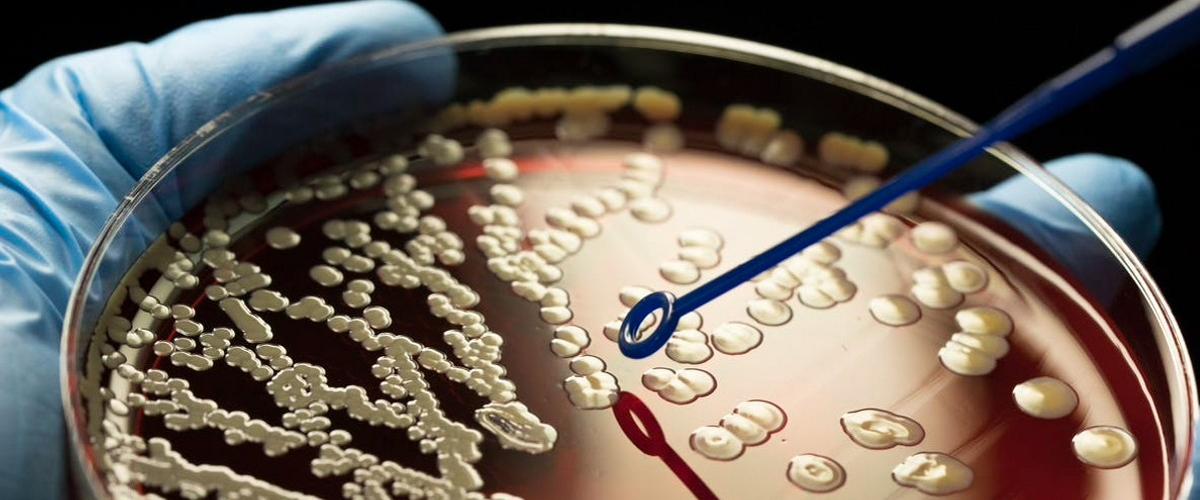
TODO:

Группа американских исследователей стремилась решить главную проблему наиболее распространенной инфекционной болезни в мире — туберкулеза. На фоне пандемии COVID-19 она отошла на второй план, однако ежегодная смертность продолжает расти, несмотря на наличие эффективной антибактериальной терапии.
Устойчивость бактерии возбудителя Mycobacterium tuberculosis к препаратам считается в мире глобальной угрозой, поэтому ученые стали искать признаки пограничного состояния, когда бактерии с наибольшей вероятностью станут резистентными.
Для этого они по образцам восстановили «генеалогическое древо» туберкулеза, чтобы идентифицировать наследственный генетический код бактерий, которые развивали резистентность, пишет Newswise. В результате масштабного анализа конкретных «ветвей древа» удалось определить ключевые изменения, связанные с развитием устойчивости. Вскоре информативность этих признаков подтвердили в независимом глобальном наборе данных по изучению туберкулеза.
«Этот подход позволит нам в будущем использовать геном патогена для выбора наилучшего лечения, — объясняет автор работы Луи Гранжан. — В данный момент у нас заканчиваются варианты антибиотиков и нередко существующая терапия достаточно токсична для пациентов».
Эти результаты стали кульминацией 17-летней исследовательской работы.
Пока авторы не сообщают, когда их открытие сможет быть интегрировано в клиническую практику, однако, безусловно, оно сможет изменить существующие схемы лечения туберкулеза. Теперь авторы рассчитывают использовать полученные результаты для поиска признаков предустойчивости других патогенов, провоцирующих тяжелые болезни.
На данный момент, продолжительность терапии туберкулеза составляет от полгода до полутора лет и даже больше. Между тем недавно были представлены результаты финальной фазы клинических испытаний, которые доказали эффективность укороченного четырехмесячного курса лечения.